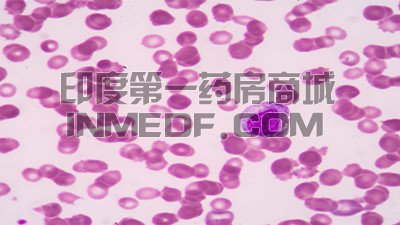
依鲁替尼

依鲁替尼副作用有哪些?

第一代Btk抑制剂依鲁替尼彻底改变了CLL和套细胞淋巴瘤的治疗方法,但该药物会引起心房颤动和出血等副...
关注度:199入库时间:2022-01-25
ibrutix依鲁替尼是一种口服的布鲁顿酪氨酸激酶(BTK)抑制剂,在临床试验中,ibrutix依鲁替尼服用后的毒...
关注度:127入库时间:2022-01-13
ibrucent又名为依鲁替尼,是一种处方药,用作布鲁顿酪氨酸激酶(BTK)的抑制剂,用于治疗至少接受过一...
关注度:191入库时间:2022-01-13
ibrucent是一种口服的布鲁顿酪氨酸激酶(BTK)抑制剂,通用名也叫依鲁替尼,在临床上可以用于治疗慢性...
关注度:90入库时间:2022-01-12
套细胞淋巴瘤(Mantle cell lymphoma,MCL)是一种特殊类型的B细胞非霍奇金淋巴瘤,主要因为染色体异常以及...
关注度:266入库时间:2021-12-30
胃MALT淋巴瘤也就是胃黏膜相关淋巴组织(MALT)淋巴瘤,是发生在胃部的一种节外非霍奇金淋巴瘤(NHL),主...
关注度:130入库时间:2021-12-29
白血病(leukemia)是一类造血干祖细胞的恶性克隆性疾病,淋巴瘤(lyphoma)也可称为恶性淋巴瘤,是起源...
关注度:303入库时间:2021-12-17
小淋巴细胞淋巴瘤(Small lymphocytic lymphoma,SLL)是一种小B细胞淋巴瘤,是慢性淋巴细胞白血病(CLL)的组...
关注度:454入库时间:2021-12-17
慢性淋巴细胞性白血病(Chronic lymphocytic leukemia,CLL)是由于骨髓产生过多的异常淋巴细胞而导致的一种恶...
关注度:272入库时间:2021-12-16